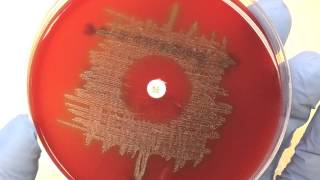

Bacteria – Microbiology | Lecturio
This video “Bacteria” is part of the Lecturio course “Microbiology” ▻ WATCH the complete course on http://lectur.io/bacteriavideocourse ▻ LEARN ABOUT: ...
Lecturio Medical
How to Become a Microbiologist | Tips, Skills you need, Salary, What it's like
This video has been requested a few times so I hope this is helpful to those who asked! This video is obviously VERY long, but no fluff. Just lots of detail.
Living like Leila
Microbiology of Medically Important Viruses
Microbiology of Medically Important Viruses microbiology medical importance of viruses medical microbiology general microbiology microbiology study recent ...
Microbiology Videos
What is a Medical Microbiologist?
What does a medical microbiologist do? Dr Shanika Crusz's role is to diagnose, treat and prevent infection caused by micro-organisms (bacteria, viruses, fungi ...
The Royal College of Pathologists
B.Sc Microbiology कोर्स के बारे में पूरी जानकारी हिंदी में - What is BSc Microbiology | Student Go |
स्वागत है आपका Student Go में !!!! हैल्लो दोस्तों...आज के इस विडियो में हम बात करने वाल...
Student Go
Micro-Biology: Crash Course History of Science #24
It's all about the SUPER TINY in this episode of Crash Course: History of Science. In it, Hank Green talks about germ theory, John Snow (the other one), ...
CrashCourse
Microbiology lecture 1 | Bacteria structure and function
Microbiology lecture 1 | Bacteria structure and function - This Microbiology lecture will explain the structure and function of bacteria including the structure and ...
Shomu's Biology
MICROBIOLOGY: A MAJOR COURSE ABOUT MINOR THINGS | CAREER GURU M.S JALIL
MICROBIOLOGY: A MAJOR COURSE ABOUT MINOR THINGS | Microbiology - കുഞ്ഞന്മാരെപ്പറ്റി പഠിക്കുന്ന വമ്പൻ കോഴ്സ്...
Career Guru
Microbiology of Bacterial Morphology & Shape
Microbiology of Bacterial Morphology & Shape microbiology lab practical microbiology schools streptococcus pneumoniae shape realplayer download videos...
Microbiology Videos
Introduction and scope of microbiology by Solution-Pharmacy in Hindi
microbiology is the branch of science which involve the study of all living organisms which are so small in size and can be seen through naked eyes, they need a ...
Solution- Pharmacy
Bacteria Micro-organisms And Viruses | Microbiology Documentary
Bacteria are everywhere: in the ground, in the water and in the air. There's no creature on earth that's not populated by bacteria. Scientists are exploring the ...
Biological Science
Chapter 2 - The Chemistry of Microbiology
This chapter looks at atoms, bonds, pH and organic molecules. Good review of chemistry we see in microbiology.
Edward Kerschen
المحاضرة الأولى في الكائنات الدقيقة الطبية لطلاب التمريض | Introduction to Microbiology
المحاضرة الأولى في الكائنات الدقيقة الطبية لطلاب التمريض للفصل الدراسي الثاني للعام الجامعي ١٤٣٧ / ١٤٣٨...
د.محمد آل قمبر
Microbiology career jobs and salary | What to do after Bsc in Microbiology?
S, what to do after Bsc in Microbiology? Microbiology career jobs and salary - This lecture explains about the career opportunity after completing Microbiology ...
Shomu's Biology
B.Sc microbiology/ b.sc microbiology course details in Tamil/b.sc microbiology jobs and salary
Eligibility criteria and Admission procedure 50% marks in 12 th No entrance exam Watch video thoroughly Subscribe TODAY Share your experiences ...
Pudhu Vazhkai
The History of Microbiology in English - Microbiology with Sumi
This video is about the History of Microbiology. #Historyofmicrobiology#Microbiology You can purchase Microbiology Books from the link given below ...
Microbiology with Sumi
Microbiologist Salary (2020) – Microbiologist Jobs
Microbiologists study microorganisms such as bacteria, viruses, algae, fungi, and some types of parasites. They try to understand how these organisms live, ...
CareerWatch
Dr. Preeti Sharma discussing Staphylococcus in Microbiology | Free Video # 6
Get one free video every week by subscribing to Drmentors Telegram channel: https://t.me/drmentors.
Drmentors
How to study for MICROBIOLOGY + Tips
Hello loves today's video is going to be on me showing you guys the material I use to study for microbiology! Microbiology Professor: ...
Nurse Aliciaa
Expectations vs Reality | Microbiology edition
When students opt for Microbiology courses, teachers expect them to behave in a particular way. But we all know how that story goes... Students mess up every ...
Laugh Like Hrishi
How to: streak plating for microbiology (take 5)
This video shows the recording of streaking technique from a right hand side view Aim of video: assess angle of recording assess lighting issues highlight ...
sade Allison
CAREERS IN B.Sc MICROBIOLOGY - M.Sc,DEGREE,Job Opportunities,Salary Package
B.Sc MICROBIOLOGY CAREERS. Go through the career opportunities of B.Sc MICROBIOLOGY, Govt Jobs and Employment News channel from ...
Freshersworld.com
MSc microbiology dissertation,microbiology research,Breach Candy Hospital Mumbai
Microbiology,molecular biology,biochemistry,serology,immunology are all part of the lab at Breach Candy Hospital.One can choose to do research projects in ...
Riitu Chaandel
Easy exam tricks in microbiology for sterilization disinfection kya hai? 100% exam.hin
Easy exam tricks in microbiology for sterilization disinfection kya hai? 100% exam.hindi.for Mbbs BDS MDS bpt nursing students.
EASY MICROBIOLOGY
Microbiology of Microbial Genetics
Microbiology of Microbial Genetics science virus dna microbiology genome biotechnology biology genes genetic engineering e coli dna replication chemistry...
Microbiology Videos
Crash Course Microbiology
Discover our eBooks and Audiobooks on Google Play Store https://play.google.com/store/books/author?id=IntroBooks Apple Books ...
IntroBooks Education
Microbiology - Bacteria Growth, Reproduction, Classification
http://armandoh.org/ https://www.facebook.com/ArmandoHasudungan Support me: http://www.patreon.com/armando Instagram: ...
Armando Hasudungan
Career in Microbiology | Part-1
Do you want to choose Microbiology as your career? Would you like to see and study the tiny microbes that you have never seen before. A degree in ...
Microbiology Mantra
Introduction to Microbiology: Microbes & Bacteria – Microbiology| Lecturio
This video “Introduction to Microbiology: Microbes & Bacteria” is part of the Lecturio course “Microbiology” ▻ WATCH the complete course on ...
Lecturio Medical
? Pharmacy vs Microbiology vs Biochemistry | Subject Review
ফার্মেসী ,মাইক্রোবায়োলজি ও বায়োকেমিস্ট্রি; এই তিনটি বিষয় নিয়ে স্টুডেন্টস...
NEURON PLUS
Introduction to Microbiology Culture Techniques
Nicole Gentile, PhD Candidate, provides an overview of basic microbiology and the concepts involved, including the bacterial growth curve and classifying ...
POCTCTR
Medical Terminology - The Basics - Microbiology and Infectious Diseases
Lesson on Medical Terminology, The Basics: Microbiology and Infectious Diseases including Bacteria, Viruses and Fungi. In this lesson, we discuss a variety of ...
JJ Medicine
MUST TO KNOW + MNEMONICS (MICROBIOLOGY)
This video is a MUST WATCH. Especially because it's all about Microbiology. Everyone says Microbiology is the hardest subject in the Board exam. So I hope in ...
Dayanara Annil
Day in the Life - Microbiology / Virology - Prof Bill Rawlinson
Microbiology, which deals with diseases caused by infectious agents such as bacteria, viruses, fungi and parasites. Medicine is Pathology www.rcpa.edu.au.
RCPA
what is Culture media || different classification of culture media || Microbiology
This is microbiology Video regarding ----culture media and it contain topic 1.what is culture media 2.why we are growing bacteria 3.Classification of Culture ...
Medical LABORATORY Tuition
Wastewater Microbiology
This video describes the importance of using wastewater microbes as indicator organisms to help optimize your wastewater treatment system.
Steven Myers
Why Microbiology? Scientists Share their Stories
Members of the American Society for Microbiology share their stories of how they discovered microbiology. To learn more about becoming a member visit ...
American Society for Microbiology
Coronavirus | Microbiology Video | Medical Online Education | V-Learning | sqadia.com
This sqadia.com coronavirus animated tutorial will help medical students learn about coronavirus Microbiology. This coronavirus animation explains the ...
sqadia.com
Microbiology - Optochin
This video is for instructional uses only and is not to be used for actual medical laboratory testing.
Patrick Tracy
USMLE Live Stream -- First Aid 2019 -- Microbiology 1
Current Section -- Bacteriology! -- FIRST AID 2019 STEP 1 Want to buy my PDF? Have a question? Email me -- usmle.live2018@gmail.com Private tutoring can ...
Amir Mullick
Microbiology: Voges-Proskauer Test
Catalyst University
Go Inside a Clinical Microbiology Lab
Go inside a clinical microbiology lab at Penn State Milton S. Hershey Medical Center and learn about careers in clinical microbiology.
American Society for Microbiology